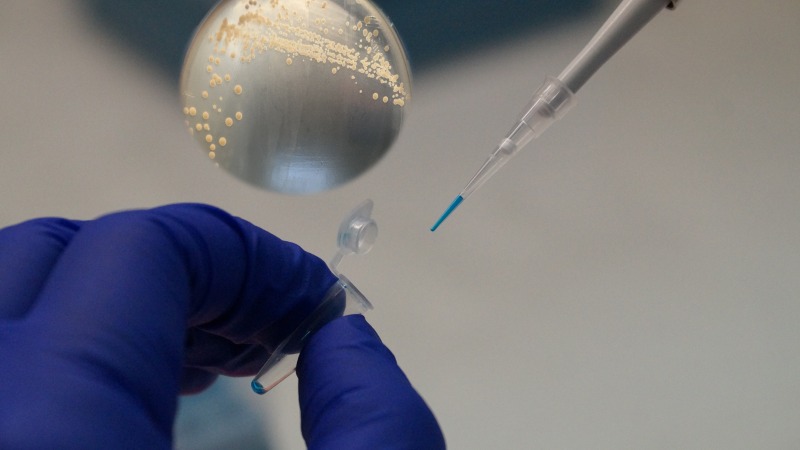

- El producto previene la infección por Helicobacter pylori y fue transferido gracias al apoyo colaborativo de la Oficina de Transferencia y Licenciamiento de la Universidad de Concepción y Hub APTA, quienes lograron la licencia comercial a Liva Company. Esta compañía chilena anunció su lanzamiento para el primer semestre de 2023 en nuestro país y explora su comercialización en Brasil. Adicionalmente, se está negociando otro acuerdo con un productor italiano para acceder a mercados de Europa, Asia y Asia Pacífico.
Hub APTA anunció un nuevo hito del probiótico apoyado por medio del programa Fill the Gap y desarrollado por la Dra. Apolinaria García Cancino, directora del laboratorio de Patogenicidad Bacteriana de la Universidad de Concepción (UdeC), quien descubrió una cepa probiótica, Lactobacillus fermentum UCO979c, capaz de impedir que el Helicobacter pylori prospere en el estómago humano, una bacteria que es responsable de hasta un 90% del cáncer de estómago y que afecta desde un 30 a 70% de los chilenos. García desarrolló un probiótico que previene la infección por esta bacteria y que acaba de cerrar una licencia nacional a Liva Company para su comercialización en 2023.
El programa Fill The Gap es un fondo brecha de APTA que busca acelerar la transferencia, negociación y comercialización de tecnologías maduras desarrolladas por los investigadores de sus entidades socias. Con este propósito, APTA financia aquellas actividades de los equipos seleccionados que sean relevantes para la validación tecnológica y el cierre de acuerdos comerciales para avanzar en la transferencia de sus invenciones. La iniciativa cuenta con el apoyo de CORFO.
La Dra. Apolinaria García Cancino, directora del laboratorio de Patogenicidad Bacteriana de la Universidad de Concepción, cuenta con 20 años de trayectoria en la investigación del Helicobacter pylori, una bacteria responsable de causar una serie de patologías gástricas, incluido el cáncer de estómago y de colon. Además, su alta presencia entre los chilenos es inusual, lo que la inspiró para buscar métodos para tratar la infección, y al mismo tiempo, prevenirla.
En esta búsqueda, la Dra. Apolinaria dio con una cepa de probiótica capaz de impedir que H. pylori prospere en el estómago humano. En un estudio clínico, realizado para evaluar la funcionalidad y efectividad de la cepa, se demostró que solo el 2,7% de voluntarios que recibieron el probiótico resultaron infectados por H. pylori; en el grupo placebo, en cambio, la infección llegó al 34.2%. La investigación lograba así un resultado prometedor, al mostrar que el consumo de este probiótico reduce el riesgo de contraer el patógeno, con una eficacia de al menos un 92.1%.
Con los resultados obtenidos, la Oficina de Transferencia y Licenciamiento de la Universidad de Concepción y la colaboración de Hub APTA, iniciaron conversaciones con la empresa biotecnológica nacional Liva Company, interesada en licenciar el nuevo producto. La cepa tiene la capacidad de fortalecer al sistema inmune, evitando que la bacteria Helicobacter pylori se aloje en el estómago. El trabajo minucioso de la investigadora y su equipo ha permitido estandarizar rápidamente el cultivo de la cepa, por lo que Liva Company ya prepara su lanzamiento para el primer semestre de 2023, ayudando a cerca de 12,6 millones de chilenos y chilenas a prevenir la infección o reinfección del patógeno.
Andrea Catalán Lobos, directora ejecutiva de OTL UdeC, precisó: “El camino para alcanzar madurez en un resultado de I+D de esta naturaleza es lento, complejo y caro en países como el nuestro y solo un compromiso superior como el de impactar a la sociedad, un liderazgo como el de esta investigadora y el apoyo institucional permanente, permite llegar hasta este momento, que celebramos todos. La participación de nuestro socio, Hub APTA, ha sido crucial para esta última etapa, permitiendo el acercamiento con empresas biotecnológicas de Chile y el mundo, y así llevar esta solución a una escala global”.
Varinka Farren, directora ejecutiva de APTA, destacó los resultados de este esfuerzo colectivo de transferencia tecnológica e innovación con base científica, y añadió que el reciente logro de Apolinaria, no implica en absoluto un descanso, sino más bien el impulso para continuar investigando en otras patologías de alta prevalencia. “Así, la experiencia y conocimientos acumulados en el estudio de probióticos, la llevan junto a su equipo a trabajar hoy en el combate de otra enfermedad inflamatoria común: el acné. Enfocada esta vez en complementar el tratamiento, avanza en la formulación de un cosmético que aprovecha las propiedades probióticas de una cepa capaz de combatir a la bacteria Cutibacterium acnes, responsable de este padecimiento”.
Catalina Garrido Rojas, cofundadora y directora técnica de Liva Company, indicó: “Estamos convencidos que la sinergia y colaboración entre la academia y el sector productivo es clave para desarrollarnos de forma más acelerada como país. Estamos muy contentos con el cierre de este hito de transferencia tecnológica y de ser responsables de que el probiótico llegue al mercado nacional y regional”.
El producto creado por la Dra. García está siendo evaluado también para ser licenciado a Italia, a través de la empresa Sacco System, quienes podrían comercializar el probiótico a sus mercados en Europa, Asia y Asia Pacífico.
Otros reconocimientos
Además de recibir el apoyo financiero de la Agencia Nacional de Investigación y Desarrollo a través de distintos fondos concursables, la Dra. Apolinaria García fue destacada en los Premios Ciencia con Impacto 2022, en la categoría “Mujer en Transferencia Tecnológica”, por liderar diversas tecnologías basadas en el estudio de patógenos gastrointestinales y probióticos. Su liderazgo y tenacidad también fue distinguido por en la XVI Ceremonia de Premiación Avonni, organizados por la fundación Foro Innovación, el Ministerio de Ciencia, Tecnología, Conocimiento e Innovación, El Mercurio y TVN. En la oportunidad, resultó ganadora junto a su equipo en las categorías Salud y Ciencia Roche por el desarrollo de la cepa UCO979c y en Premio a la Mujer Innovadora 2022.